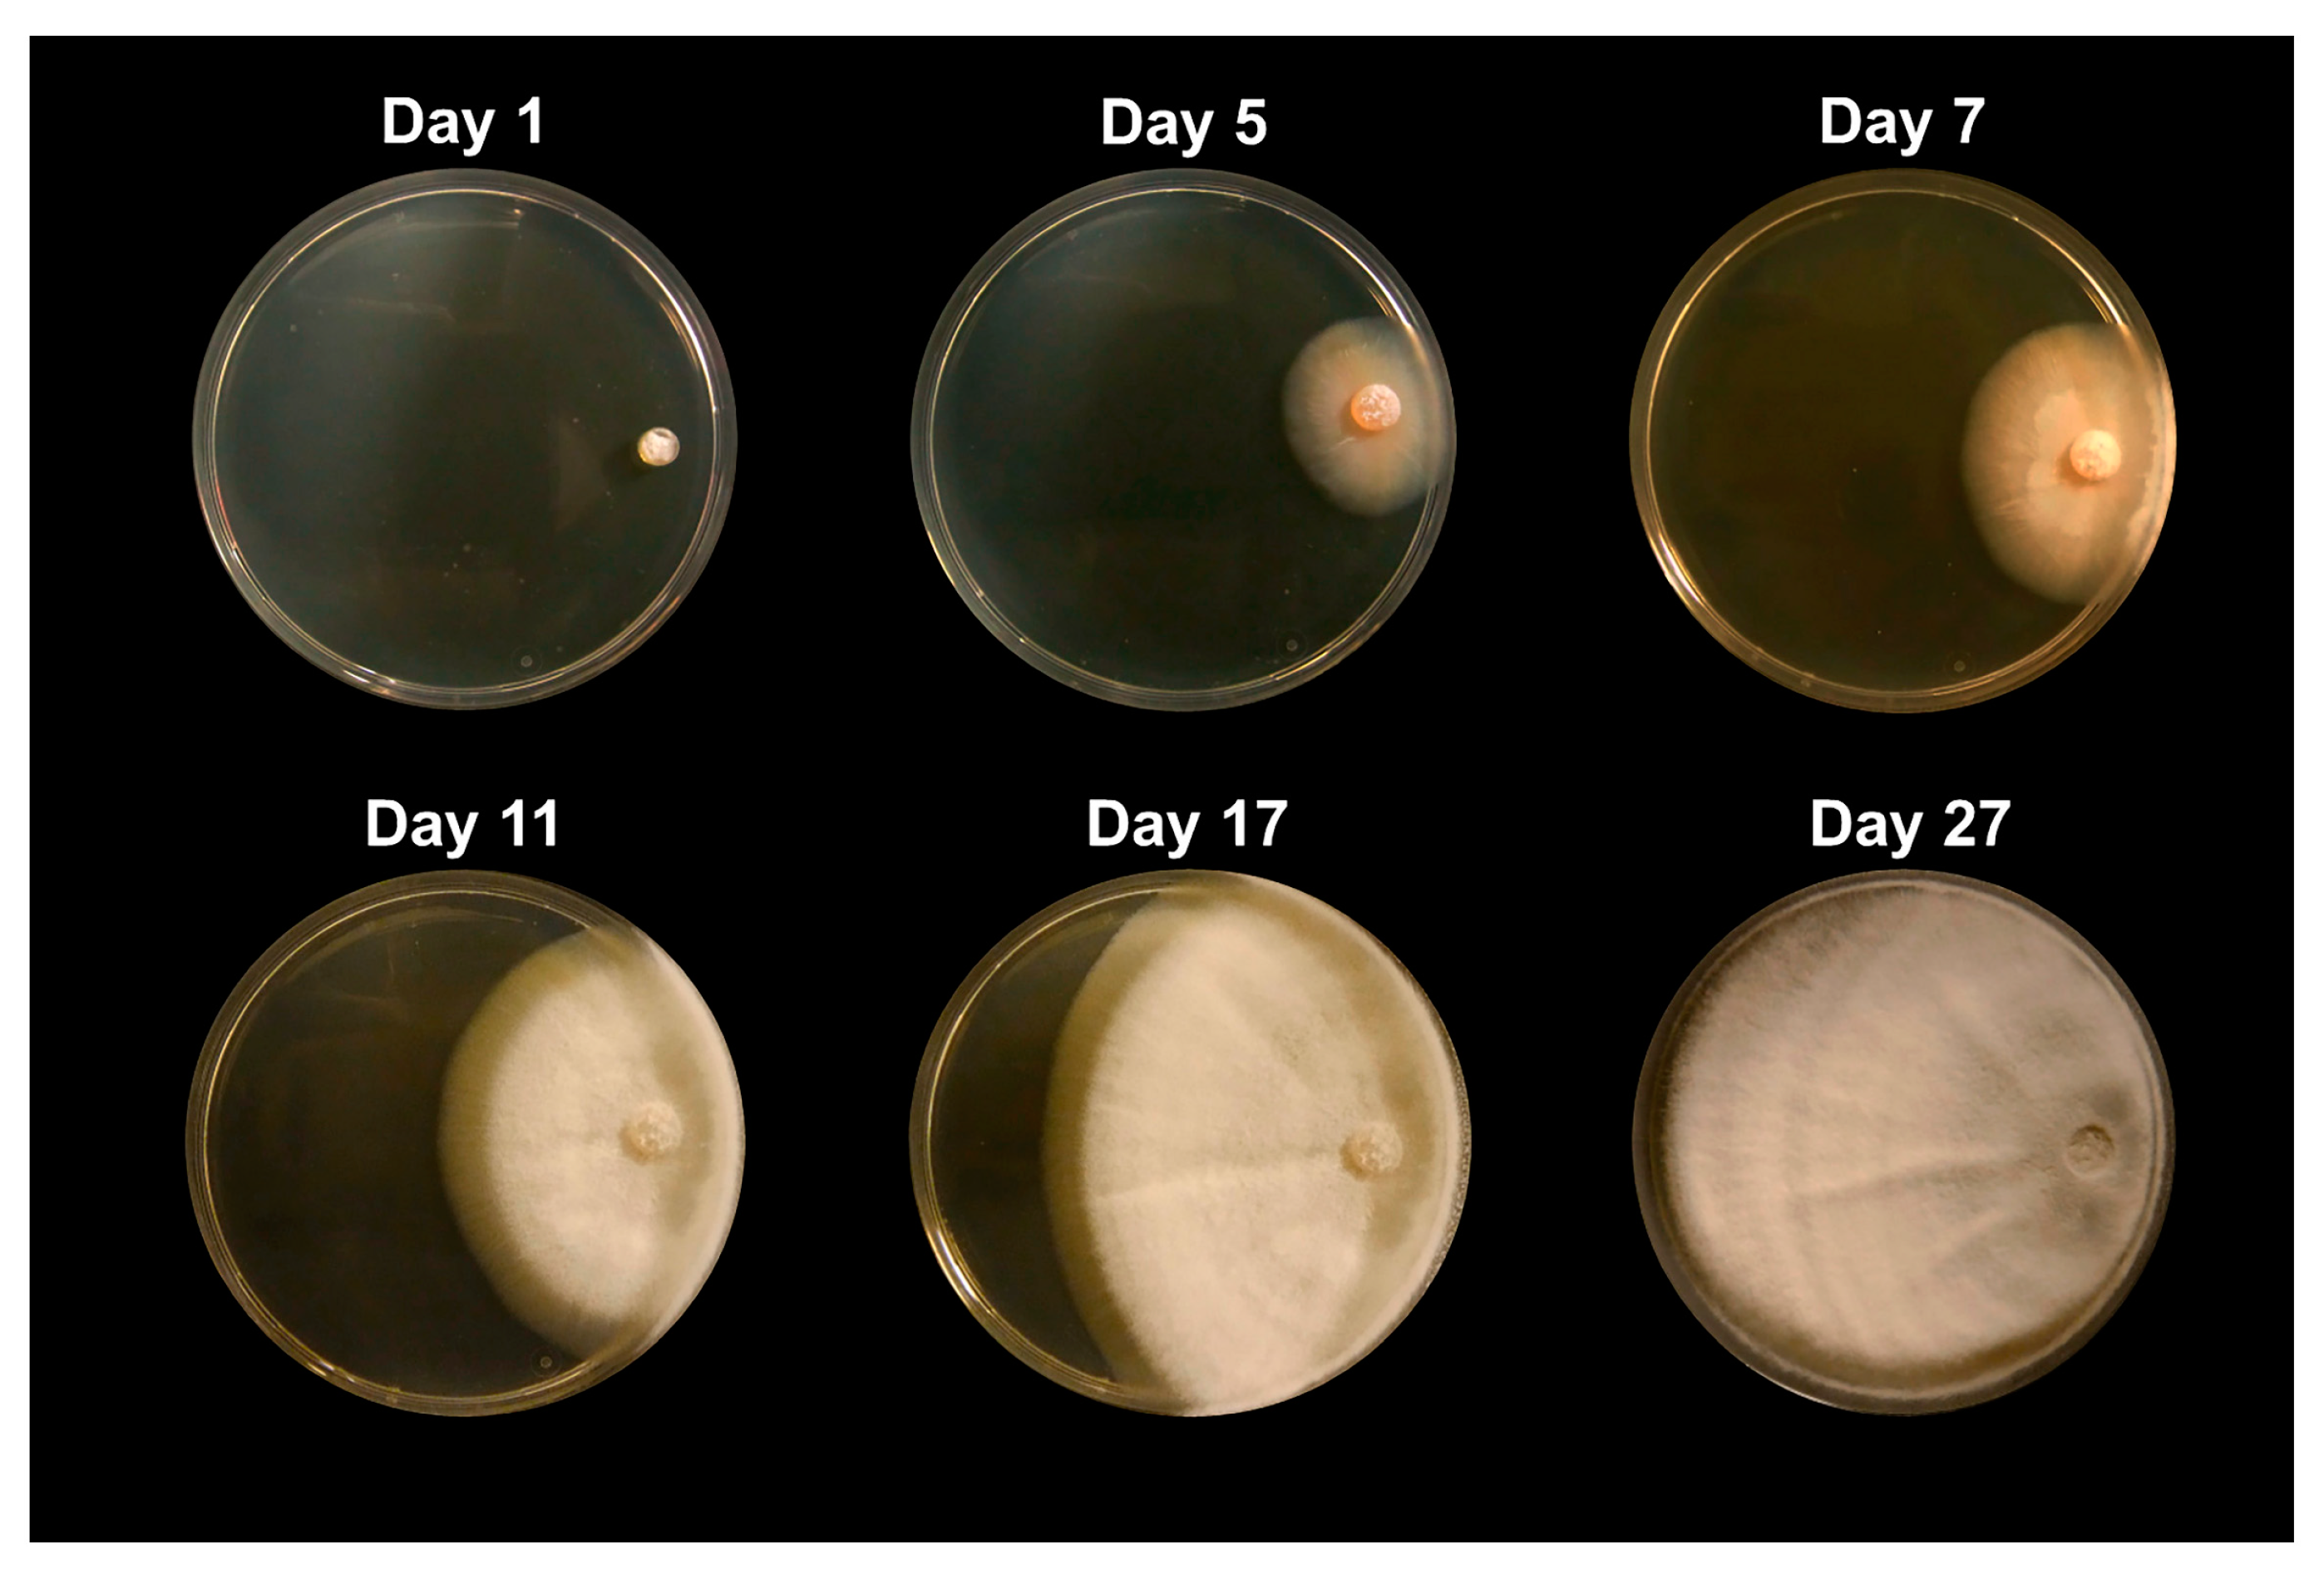
Jof 09 00345 g001

Combating the Dust Devil: Utilizing Naturally Occurring Soil Microbes in Arizona to Inhibit the Growth of Coccidioides spp., the Causative Agent of Valley Fever
Abstract
:1. Introduction
2. Methods
2.1. Soil Collection
2.2. Microbial Isolation
2.3. DNA Extraction and Molecular Identification
2.4. Sequencing
2.5. Challenge Assays
2.6. Metabolite Extraction
2.7. Analytical Chemistry
2.8. Statistical Analysis
3. Results
3.1. Microbial Identification
3.2. Challenge Assays
3.3. Metabolite Separation and Analysis
4. Discussion
5. Study Limitations
Supplementary Materials
Author Contributions
Funding
Institutional Review Board Statement
Informed Consent Statement
Data Availability Statement
Acknowledgments
Conflicts of Interest
References
- Castro, H.F.; Classen, A.T.; Austin, E.E.; Norby, R.J.; Schadt, C.W. Soil microbial community responses to multiple experimental climate change drivers. Appl. Environ. Microbiol. 2010, 76, 999–1007. [Google Scholar] [CrossRef] [Green Version]
- Fierer, N.; Schimel, J.P.; Holden, P.A. Variations in microbial community composition through two soil depth profiles. Soil Biol. Biochem. 2003, 35, 167–176. [Google Scholar] [CrossRef]
- Boer, W.D.; Folman, L.B.; Summerbell, R.C.; Boddy, L. Living in a fungal world: Impact of fungi on soil bacterial niche development. FEMS Microbiol. Rev. 2005, 29, 795–811. [Google Scholar] [CrossRef] [PubMed] [Green Version]
- Meidute, S.; Demoling, F.; Bååth, E. Antagonistic and synergistic effects of fungal and bacterial growth in soil after adding different carbon and nitrogen sources. Soil Biol. Biochem. 2008, 40, 2334–2343. [Google Scholar] [CrossRef]
- Barker, B.M.; Tabor, J.A.; Shubitz, L.F.; Perrill, R.; Orbach, M.J. Detection and phylogenetic analysis of Coccidioides posadasii in Arizona soil samples. Fungal Ecol. 2012, 5, 163–176. [Google Scholar] [CrossRef]
- Campins, H. Coccidioidomycosis in South America. A review of its epidemiology and geographic distribution. Mycopathol. Mycol. Appl. 1970, 41, 25–34. [Google Scholar] [CrossRef] [PubMed]
- Fisher, M.C.; Koenig, G.L.; White, T.J.; Taylor, J.W. Molecular and phenotypic description of Coccidioides posadasii sp. nov.; previously recognized as the non-California population of Coccidioides immitis. Mycologia 2002, 94, 73–84. [Google Scholar] [CrossRef] [Green Version]
- Fisher, M.C.; Koenig, G.L.; White, T.J.; San-Blas, G.; Negroni, R.; Alvarez, I.G.; Wanke, B.; Taylor, J.W. Biogeographic range expansion into South America by Coccidioides immitis mirrors New World patterns of human migration. Proc. Natl. Acad. Sci. USA 2001, 98, 4558–4562. [Google Scholar] [CrossRef] [PubMed] [Green Version]
- Chow, N.A.; Griffin, D.W.; Barker, B.M.; Loparev, V.N.; Litvintseva, A.P. Molecular detection of airborne Coccidioides in Tucson, Arizona. Med. Mycol. 2016, 54, 584–592. [Google Scholar] [CrossRef] [Green Version]
- McCotter, O.Z.; Benedict, K.; Engelthaler, D.M.; Komatsu, K.; Lucas, K.D.; Mohle-Boetani, J.C.; Oltean, H.; Vugia, D.; Chiller, T.M.; Sondermeyer Cooksey, G.L.; et al. Update on the Epidemiology of coccidioidomycosis in the United States. Med. Mycol. 2019, 57 (Suppl. 1), S30–S40. [Google Scholar] [CrossRef]
- Comrie, A.C. Climate factors influencing coccidioidomycosis seasonality and outbreaks. Environ. Health Perspect. 2005, 113, 688–692. [Google Scholar] [CrossRef] [PubMed]
- Elconin, A.F.; Egeberg, R.O.; Egeberg, M.C. Significance of Soil Salinity on the Ecology of Coccidioides immitis. J. Bacteriol. 1964, 87, 500–503. [Google Scholar] [CrossRef] [Green Version]
- Fisher, F.S.; Bultman, M.W.; Johnson, S.M.; Pappagianis, D.; Zaborsky, E. Coccidioides niches and habitat parameters in the southwestern United States: A matter of scale. Ann. N. Y. Acad. Sci. 2007, 1111, 47–72. [Google Scholar] [CrossRef] [PubMed] [Green Version]
- Gorris, M.E.; Cat, L.A.; Zender, C.S.; Treseder, K.K.; Randerson, J.T. Coccidioidomycosis dynamics in relation to climate in the southwestern United States. GeoHealth 2018, 2, 6–24. [Google Scholar] [CrossRef]
- Kolivras, K.N.; Comrie, A.C. Modeling valley fever (coccidioidomycosis) incidence on the basis of climate conditions. Int. J. Biometeorol. 2003, 47, 87–101. [Google Scholar] [CrossRef] [PubMed]
- Kolivras, K.N.; Johnson, P.S.; Comrie, A.C.; Yool, S.R. Environmental Variability and coccidioidomycosis (valley fever). Aerobiologia 2001, 17, 31–42. [Google Scholar] [CrossRef]
- Maddy, K.T. Ecological factors of the geographic distribution of Coccidioides immitis. J. Am. Vet. Med. Assoc. 1957, 130, 475–476. [Google Scholar] [PubMed]
- Tamerius, J.D.; Comrie, A.C. Coccidioidomycosis incidence in Arizona predicted by seasonal precipitation. PLoS ONE 2011, 6, e21009. [Google Scholar] [CrossRef] [PubMed] [Green Version]
- Weaver, E.; Kolivras, K.N.; Thomas, R.Q.; Thomas, V.A.; Abbas, K.M. Environmental factors affecting ecological niche of Coccidioides species and spatial dynamics of valley fever in the United States. Spat. Spatio-Temporal Epidemiol. 2020, 32, 100317. [Google Scholar] [CrossRef]
- Weaver, E.A.; Kolivras, K.N. Investigating the Relationship between Climate and Valley Fever (Coccidioidomycosis). Ecohealth 2018, 15, 840–852. [Google Scholar] [CrossRef]
- Alvarado, P.; Teixeira, M.D.M.; Andrews, L.; Fernandez, A.; Santander, G.; Doyle, A.; Perez, M.; Yegres, F.; Barker, B.M. Detection of Coccidioides posadasii from xerophytic environments in Venezuela reveals risk of naturally acquired coccidioidomycosis infections. Emerg. Microbes Infect. 2018, 7, 1–13. [Google Scholar] [CrossRef] [Green Version]
- Lauer, A.; Baal, J.D.; Mendes, S.D.; Casimiro, K.N.; Passaglia, A.K.; Valenzuela, A.H.; Guibert, G. Valley fever on the rise—Searching for microbial antagonists to the fungal pathogen Coccidioides immitis. Microorganisms 2019, 7, 31. [Google Scholar] [CrossRef] [PubMed] [Green Version]
- Orr, G. Some fungi isolated with Coccidioides immitis from soils of endemic areas in California. Bull. Torrey Bot. Club 1968, 95, 424–431. [Google Scholar] [CrossRef]
- Kathiravan, M.K.; Salake, A.B.; Chothe, A.S.; Dudhe, P.B.; Watode, R.P.; Mukta, M.S.; Gadhwe, S. Biology and chemistry of antifungal agents: A review. Bioorganic Med. Chem. 2012, 20, 5678–5698. [Google Scholar] [CrossRef] [PubMed]
- Kerr, J.R. Bacterial inhibition of fungal growth and pathogenicity. Microb. Ecol. Health Dis. 1999, 11, 129–142. [Google Scholar]
- Chan, Y.-K.; McCormick, W.A.; Seifert, K.A. Characterization of an antifungal soil bacterium and its antagonistic activities against Fusarium species. Can. J. Microbiol. 2003, 49, 253–262. [Google Scholar] [CrossRef]
- Junaid, J.M.; Dar, N.A.; Bhat, T.A.; Bhat, A.H.; Bhat, M.A. Commercial biocontrol agents and their mechanism of action in the management of plant pathogens. Int. J. Mod. Plant Anim. Sci. 2013, 1, 39–57. [Google Scholar]
- Kollath, D.R.; Teixeira, M.M.; Funke, A.; Miller, K.J.; Barker, B.M. Investigating the Role of Animal Burrows on the Ecology and Distribution of Coccidioides spp. in Arizona Soils. Mycopathologia 2019, 185, 145–159. [Google Scholar] [CrossRef]
- Bowers, J.R.; Parise, K.L.; Kelley, E.J.; Lemmer, D.; Schupp, J.M.; Driebe, E.M.; Engelthaler, D.M.; Keim, P.; Barker, B.M. Direct detection of Coccidioides from Arizona soils using CocciENV, a highly sensitive and specific real-time PCR assay. Med. Mycol. 2019, 57, 246–255. [Google Scholar] [CrossRef] [Green Version]
- Edwards, U.; Rogall, T.; Blöcker, H.; Emde, M.; Böttger, E.C. Isolation and direct complete nucleotide determination of entire genes. Characterization of a gene coding for 16S ribosomal RNA. Nucleic Acids Res. 1989, 17, 7843–7853. [Google Scholar] [CrossRef] [Green Version]
- White, T.J.; Bruns, T.; Lee, S.J.W.T.; Taylor, J. Amplification and direct sequencing of fungal ribosomal RNA genes for phylogenetics. PCR Protoc. Guide Methods Appl. 1990, 18, 315–322. [Google Scholar]
- LaCourse, M.E.; LaCourse, W.R. General instrumentation in HPLC. In Liquid Chromatography; Elsevier: Amsterdam, The Netherlands, 2017; pp. 417–429. [Google Scholar]
- Singhal, N.; Kumar, M.; Kanaujia, P.K.; Virdi, J.S. MALDI-TOF mass spectrometry: An emerging technology for microbial identification and diagnosis. Front. Microbiol. 2015, 6, 791. [Google Scholar] [CrossRef] [Green Version]
- Sud, M.; Fahy, E.; Cotter, D.; Azam, K.; Vadivelu, I.; Burant, C.; Edison, A.; Fiehn, O.; Higashi, R.; Nair, K.S.; et al. Metabolomics Workbench: An international repository for metabolomics data and metadata, metabolite standards, protocols, tutorials and training, and analysis tools. Nucleic Acids Res. 2016, 44, D463–D470. [Google Scholar] [CrossRef] [Green Version]
- Alvarez-Ordóñez, A.; Prieto, M. Technical and methodological aspects of fourier transform infrared spectroscopy in food microbiology research. In Fourier Transform Infrared Spectroscopy in Food Microbiology; Springer: Berlin, Germany, 2012; pp. 1–18. [Google Scholar]
- Blumer, M.R.; Chang, C.H.; Brayfindley, E.; Nunez, J.R.; Colby, S.M.; Renslow, R.S.; Metz, T.O. Mass Spectrometry Adduct Calculator. J. Chem. Inf. Modeling 2021, 61, 5721–5725. [Google Scholar] [CrossRef] [PubMed]
- Huang, N.; Siegel, M.M.; Kruppa, G.H.; Laukien, F.H. Automation of a Fourier transform ion cyclotron resonance mass spectrometer for acquisition, analysis, and e-mailing of high-resolution exact-mass electrospray ionization mass spectral data. J. Am. Soc. Mass Spectrom. 1999, 10, 1166–1173. [Google Scholar] [CrossRef] [Green Version]
- Shih, C.; Teicher, B.A. Cryptophycins: A novel class of potent antimitotic antitumor depsipeptides. Curr. Pharm. Des. 2001, 7, 1259–1276. [Google Scholar] [CrossRef]
- Dobashi, K.; Matsuda, N.; Hamada, M.; Naganawa, H.; Takita, T.; Takeuchi, T. Novel Antifungal Antibiotics Octacosamicins, A. and, B I. Taxonomy, Fermentation and Isolation, Physico-Chemical Properties and Biological Activities. J. Antibiot. 1988, 41, 1525–1532. [Google Scholar] [CrossRef] [PubMed] [Green Version]
- Sugita, M.; Natori, Y.; Sueda, N.; Furihata, K.; Seto, H.; Otake, N. Studies on Mycotrienin Antibiotics, A Novel Class of Ansamycins Iii. The Isolation, Characterization and Structures of Mycotrienols I and Ii. J. Antibiot. 1982, 35, 1474–1479. [Google Scholar] [CrossRef] [PubMed] [Green Version]
- Welch, T.R.; Williams, R.M. Epidithiodioxopiperazines. occurrence, synthesis and biogenesis. Nat. Prod. Rep. 2014, 31, 1376–1404. [Google Scholar] [CrossRef] [Green Version]
- K Mazu, T.; A Bricker, B.; Flores-Rozas, H.; Y Ablordeppey, S. The mechanistic targets of antifungal agents: An overview. Mini Rev. Med. Chem. 2016, 16, 555–578. [Google Scholar] [CrossRef] [PubMed]
- Osada, H. Chemical and biological studies of reveromycin A. J. Antibiot. 2016, 69, 723–730. [Google Scholar] [CrossRef]
- Lakshmi, V.; Srivastava, S.; Mishra, S.K.; Shukla, P.K. Antifungal activity of bivittoside-D from Bohadschia vitiensis (Semper). Nat. Prod. Res. 2012, 26, 913–918. [Google Scholar] [CrossRef]
- Degenkolb, T.; Heinze, S.; Schlegel, B.; Dornberger, K.; Moellmann, U.; Dahse, H.M.; Graefe, U. Roseoferin, a new aminolipopeptide antibiotic complex from Mycogone rosea DSM 12973, structures and biological activities. J. Antibiot. 2000, 53, 184–190. [Google Scholar] [CrossRef] [PubMed] [Green Version]
- Chaillot, J.; Tebbji, F.; García, C.; Wurtele, H.; Pelletier, R.; Sellam, A. pH-dependant antifungal activity of valproic acid against the human fungal pathogen Candida albicans. Front. Microbiol. 2017, 8, 1956. [Google Scholar] [CrossRef] [PubMed] [Green Version]
- Yun, K.; Khong, T.T.; Leutou, A.S.; Kim, G.D.; Hong, J.; Lee, C.H.; Son, B.W. Cristazine, a new cytotoxic dioxopiperazine alkaloid from the mudflat-sediment-derived fungus Chaetomium cristatum. Chem. Pharm. Bull. 2016, 64, 59–62. [Google Scholar] [CrossRef] [PubMed] [Green Version]
- Bianchi, F.J.; Booij, C.; Tscharntke, T. Sustainable pest regulation in agricultural landscapes: A review on landscape composition, biodiversity and natural pest control. Proc. R Soc. B Biol. Sci. 2006, 273, 1715–1727. [Google Scholar] [CrossRef] [Green Version]
- Lekota, K.E.; Bezuidt, O.K.I.; Mafofo, J.; Rees, J.; Muchadeyi, F.C.; Madoroba, E.; Van Heerden, H. Whole genome sequencing and identification of Bacillus endophyticus and B. anthracis isolated from anthrax outbreaks in South Africa. BMC Microbiol. 2018, 18, 67. [Google Scholar] [CrossRef]
- Leveau, J.H.; Preston, G.M. Bacterial mycophagy: Definition and diagnosis of a unique bacterial–fungal interaction. New Phytol. 2008, 177, 859–876. [Google Scholar] [CrossRef]
- Minerdi, D.; Fani, R.; Gallo, R.; Boarino, A.; Bonfante, P. Nitrogen fixation genes in an endosymbiotic Burkholderia strain. Appl. Environ. Microbiol. 2001, 67, 725–732. [Google Scholar] [CrossRef] [PubMed] [Green Version]
- Richardson, D.H.; Cameron, R.P. Cyanolichens: Their response to pollution and possible management strategies for their conservation in northeastern North America. Northeast. Nat. 2004, 11, 1–22. [Google Scholar] [CrossRef]
- Brosnan, B.; Coffey, A.; Arendt, E.K.; Furey, A. Rapid identification, by use of the LTQ Orbitrap hybrid FT mass spectrometer, of antifungal compounds produced by lactic acid bacteria. Anal. Bioanal. Chem. 2012, 403, 2983–2995. [Google Scholar] [CrossRef] [PubMed]
- Brosnan, B.; Coffey, A.; Arendt, E.K.; Furey, A. The QuEChERS approach in a novel application for the identification of antifungal compounds produced by lactic acid bacteria cultures. Talanta 2014, 129, 364–373. [Google Scholar] [CrossRef] [PubMed]
- Islam, M.R.; Jeong, Y.T.; Lee, Y.S.; Song, C.H. Isolation and identification of antifungal compounds from Bacillus subtilis C9 inhibiting the growth of plant pathogenic fungi. Mycobiology 2012, 40, 59–65. [Google Scholar] [CrossRef] [Green Version]
- Li, H.; Liu, L.; Zhang, S.; Cui, W.; Lv, J. Identification of antifungal compounds produced by Lactobacillus casei AST18. Curr. Microbiol. 2012, 65, 156–161. [Google Scholar] [CrossRef] [PubMed]
- Zhao, X.; Zhou, Z.J.; Han, Y.; Wang, Z.Z.; Fan, J.; Xiao, H.Z. Isolation and identification of antifungal peptides from Bacillus BH072, a novel bacterium isolated from honey. Microbiol. Res. 2013, 168, 598–606. [Google Scholar] [CrossRef]
- Benedict, K.; Park, B.J. Invasive fungal infections after natural disasters. Emerg. Infect. Dis. 2014, 20, 349. [Google Scholar] [CrossRef]
- Nnadi, N.E.; Carter, D.A. Climate change and the emergence of fungal pathogens. PLoS Pathog. 2021, 17, e1009503. [Google Scholar] [CrossRef]

| Isolate ID | Species | Kingdom | Phylum | Order | Family | Accession # | Similarity (%) |
|---|---|---|---|---|---|---|---|
| Fun_5 | Circinella muscae | Fungi | Mucoromycota | Mucorales | Lichtheimiaceae | JQ683232 | 99 |
| Fun_20 | Aspergillus fruticulosus | Fungi | Ascomycota | Eurotiales | Aspergillaceae | MH858680 | 99 |
| Fun_12 | Arthroderma eboreum | Fungi | Ascomycota | Onygenales | Arthrodermataceae | LR136971 | 92 |
| Fun_11 | Aspergillus ustus | Fungi | Ascomycota | Eurotiales | Aspergillaceae | KR012899 | 99 |
| Fun_17 | Fennellomyces linderi | Fungi | Mucoromycota | Mucorales | Lichtheimiaceae | GQ249890 | 99 |
| Fun_18 | Ovatospora brasiliensis | Fungi | Ascomycota | Sordariales | Chaetomiaceae | MH858834 | 99 |
| Fun_16 | Acrophialophora levis | Fungi | Ascomycota | Sordariales | Chaetomiacae | KM995900 | 97 |
| Bac_6 | Cupriavidus gilardii | Bacteria | Proteobacteria | Burkholderiales | Burkholderiaceae | KC460407 | 99 |
| Bac_3 | Bacillus subtilis | Bacteria | Firmicutes | Bacillales | Bacillaceae | OK083734 | 99 |
| Bac_a | Brevibacillus nitrificans | Bacteria | Firmicutes | Bacillales | Bacillaceae | MT584833 | 99 |
| Bac_7 | Bacillus tequilensis | Bacteria | Firmicutes | Bacillales | Bacillaceae | MN227769 | 98 |
| Bac_5 | Bacillus cereus | Bacteria | Firmicutes | Bacillales | Bacillaceae | OK083719 | 99 |
| Bac_1 | Rhodococcus wratislaviensis | Bacteria | Actinobacteria | Corynebacteriales | Nocardiaceae | MH251267 | 99 |
| Bac_2 | Bacillus endophyticus | Bacteria | Firmicutes | Bacillales | Bacillaceae | MT588728.1 | 99 |
| Bac-22 | Bacillus pumilus | Bacteria | Firmicutes | Bacillales | Bacillaceae | OM976408.1 | 99 |
| Sample | Metabolite | Class of Compound | m/z | Reference |
|---|---|---|---|---|
| B. pumilus/C. posadasii | Cryptophycin C | Peptide C | 638.28 | [38] |
| B. pumilus/C. posadasii | Octacosamicin B | Peptide AF | 638.39 | [39] |
| B. pumilus/C. posadasii | paecilin C | ND | 638.16 | NA |
| B. pumilus/C. posadasii | Mycotrienin II (Ansatrienin B) | ND AF | 638.36 | [40] |
| B. pumilus/C. posadasii | Emethallicin D | Alkaloid AF | 688.10 | [41] |
| B. pumilus/C. posadasii | Bafilomycin N | Alkaloid AF | 688.42 | [42] |
| B. pumilus/C. posadasii | Reveromycin E | Alkaloid C | 688.38 | [43] |
| B. pumilus/C. posadasii | Cryptophycin-31 | Peptide | 688.23 | NA |
| B. pumilus/C. posadasii | Metrizamide | Peptide | 788.85 | NA |
| B. pumilus/C. posadasii | Gymnopilin B11 | ND | 1088.83 | NA |
| B. pumilus/C. posadasii | Bivittoside B | ND AF | 1088.58 | [44] |
| B. pumilus/C. posadasii | Brevetoxin B3 | ND | 1164.66 | NA |
| B. pumilus/C. posadasii | Roseoferin G | Peptide C | 1176.85 | [45] |
| B. pumilus/C. posadasii | Cyanocobalamin | ND | 1354.57 | NA |
| B. subtilis/C.posadasii | Valproyl-CoA | ND AF | 893.22 | [46] |
| B. subtilis/C.posadasii | Emethallicin D | Alkaloid AF | 688.10 | [41] |
| B. subtilis/C.posadasii | Cristazine | Alkaloid C | 688.20 | [47] |
| B. subtilis/C.posadasii | Cryptophycin-31 | Peptide C | 688.23 | NA |
| B. subtilis/C.posadasii | Metrizamide | Peptide | 788.85 | NA |
Disclaimer/Publisher’s Note: The statements, opinions and data contained in all publications are solely those of the individual author(s) and contributor(s) and not of MDPI and/or the editor(s). MDPI and/or the editor(s) disclaim responsibility for any injury to people or property resulting from any ideas, methods, instructions or products referred to in the content. |
© 2023 by the authors. Licensee MDPI, Basel, Switzerland. This article is an open access article distributed under the terms and conditions of the Creative Commons Attribution (CC BY) license (https://creativecommons.org/licenses/by/4.0/).
Share and Cite
Kollath, D.R.; Morales, M.M.; Itogawa, A.N.; Mullaney, D.; Lee, N.R.; Barker, B.M. Combating the Dust Devil: Utilizing Naturally Occurring Soil Microbes in Arizona to Inhibit the Growth of Coccidioides spp., the Causative Agent of Valley Fever. J. Fungi 2023, 9, 345. https://doi.org/10.3390/jof9030345
Kollath DR, Morales MM, Itogawa AN, Mullaney D, Lee NR, Barker BM. Combating the Dust Devil: Utilizing Naturally Occurring Soil Microbes in Arizona to Inhibit the Growth of Coccidioides spp., the Causative Agent of Valley Fever. Journal of Fungi. 2023; 9(3):345. https://doi.org/10.3390/jof9030345
Chicago/Turabian StyleKollath, Daniel R., Matthew M. Morales, Ashley N. Itogawa, Dustin Mullaney, Naomi R. Lee, and Bridget M. Barker. 2023. "Combating the Dust Devil: Utilizing Naturally Occurring Soil Microbes in Arizona to Inhibit the Growth of Coccidioides spp., the Causative Agent of Valley Fever" Journal of Fungi 9, no. 3: 345. https://doi.org/10.3390/jof9030345





